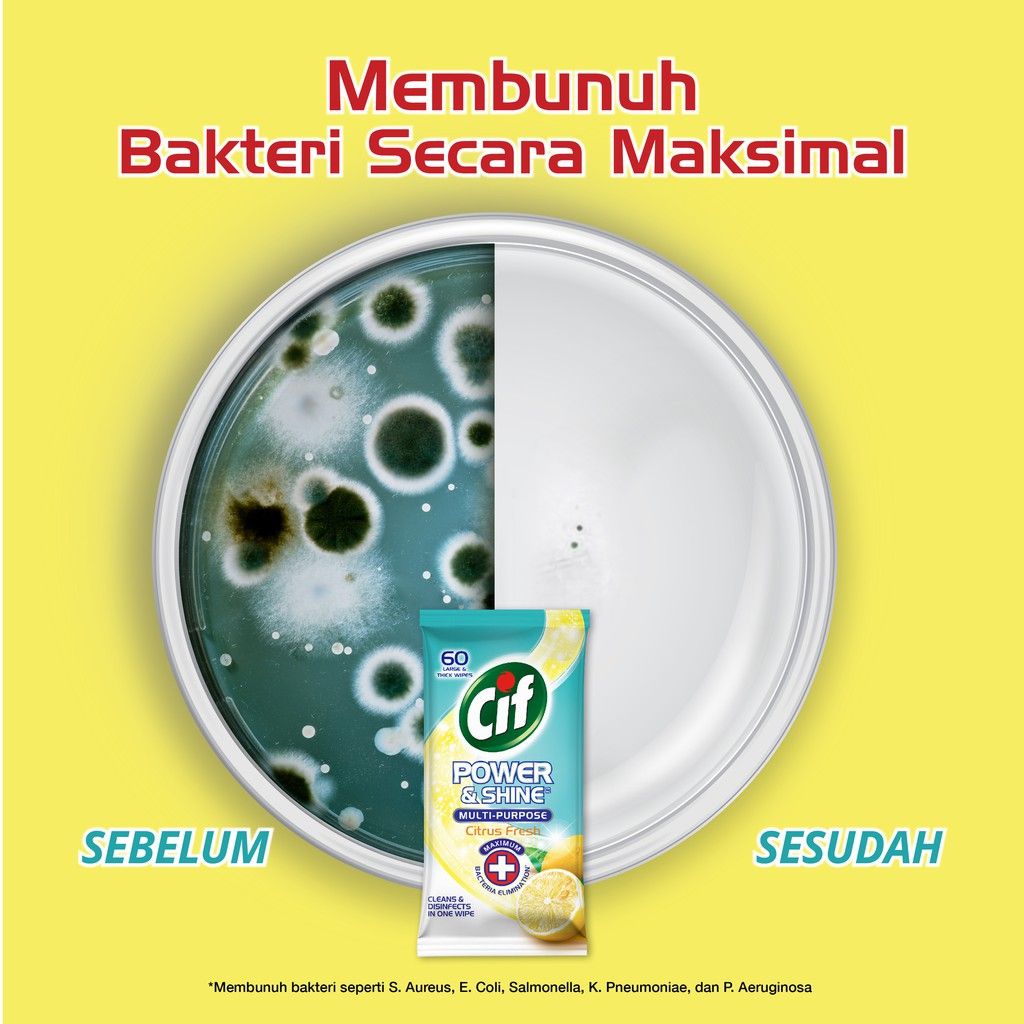
CIF Power & Shine Multipurpose Citrus Fresh 60s - 5

CIF Power & Shine Multipurpose Citrus Fresh 60s
Rp48.900
Deskripsi produk
CIF Power & Shine Disinfectant Multipurpose Wipes Citrus Fresh 60s
"Dengan CIF Power & Shine Disinfectant Multipurpose Wipes, Anda dapat membersihkan dan mendisinfeksi permukaan dalam satu kali lap, dengan kekuatan untuk mengangkat kotoran dan lemak membandel pada permukaan, tisu ini bagus untuk segala hal mulai dari wastafel hingga stainless steel, kompor hingga tempat sampah, toilet, meja dan permukaan lainnya. CIF Power & Shine Disinfectant Multipurpose Wipes adalah solusi praktis untuk membersihkan semua kotoran yang terlihat dan tidak terlihat di sekitar rumah Anda. Tisu serbaguna ini membersihkan semua jenis kotoran, meninggalkan kilau dan keharuman yang indah. Tisu Cif dirancang khusus dengan tambahan kekuatan disinfektan untuk perlindungan maksimal lawan bakteri*. Di Cif, kami percaya bahwa rumah bersih yang berkilau adalah kebahagiaan untuk ditinggali. Kami percaya dalam mengungkapkan dan melindungi keindahan semua permukaan rumah Anda untuk dinikmati semua orang, setiap hari. Itulah sebabnya selama lebih dari 50 tahun, Cif telah mengembangkan berbagai produk pembersih inovatif yang menghilangkan kotoran jelek, tanpa merusak permukaan memberikan Anda hasil yang indah. Untuk rumah higenis yang bersih cemerlang, gunakan CIF Power & Shine Disinfectant Multipurpose Wipes bersama dengan Cif Multipurpose Disinfectant Spray *berdasarkan hasil uji lab terakreditasi: S.Aureus, E. Coli, Salmonella Thypimuirum, P.Aeruginosa, Candida albicans." Disinfeksi dengan perlindungan maksimal Mengangkat noda membandel pada permukaan seperti dapur, wastafel, meja, toilet, dll Dilengkapi dengan keharuman yang segar.
Isi Produk
- 1 x CIF Power & Shine Disinfectant Multipurpose Wipes Citrus Fresh 60s